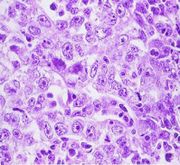

File list
Jump to navigation
Jump to search
This special page shows all uploaded files.
| Date | Name | Thumbnail | Size | User | Description | Versions |
|---|---|---|---|---|---|---|
| 11:09, 31 August 2007 | Sarcoma embolus.jpg (file) |  |
74 KB | Kjr35 | 1 | |
| 11:11, 31 August 2007 | Parvovirus dog.jpg (file) |  |
131 KB | Kjr35 | 1 | |
| 11:13, 31 August 2007 | Hypertrophic cardiomyopathy.jpg (file) |  |
57 KB | Kjr35 | 1 | |
| 11:14, 31 August 2007 | Hypertrophic cardiomyopathy 2.jpg (file) |  |
82 KB | Kjr35 | 1 | |
| 11:17, 31 August 2007 | Dirofilariasis.jpg (file) |  |
69 KB | Kjr35 | 1 | |
| 11:17, 31 August 2007 | Dirofilariasis 2.jpg (file) |  |
72 KB | Kjr35 | 1 | |
| 11:23, 31 August 2007 | Aortic mineralisation.jpg (file) |  |
65 KB | Kjr35 | 1 | |
| 11:28, 31 August 2007 | Hand burn injury.jpg (file) |  |
90 KB | Kjr35 | 1 | |
| 11:30, 31 August 2007 | Oral squamous cell carcinoma.jpg (file) |  |
83 KB | Kjr35 | 1 | |
| 11:32, 31 August 2007 | Thigh muscles atrophy.jpg (file) |  |
71 KB | Lizzies | Atrophy of the thigh muscles of the dog. The left hand side shows the atrophied muscles, whereas the right hand side shows the normal limb on the other side. Pending permission from Brian Smyth. | 1 |
| 11:35, 31 August 2007 | Muscle atrophy.jpg (file) |  |
31 KB | Lizzies | Histological appearance of muscle atrophy. Pending permission from Brian Smyth. | 1 |
| 11:36, 31 August 2007 | Thyroid adenoma.jpg (file) |  |
76 KB | Kjr35 | 1 | |
| 11:38, 31 August 2007 | Renal carcinoma.jpg (file) |  |
97 KB | Kjr35 | 1 | |
| 11:39, 31 August 2007 | Kidney infarct.jpg (file) |  |
82 KB | Kjr35 | 1 | |
| 11:41, 31 August 2007 | Hydronephrosis.jpg (file) |  |
101 KB | Kjr35 | 1 | |
| 11:42, 31 August 2007 | Human anthrax.jpg (file) |  |
74 KB | Kjr35 | 1 | |
| 11:45, 31 August 2007 | Obstructional hypertrophy bladder.jpg (file) |  |
27 KB | Lizzies | Hypertrophy of the bladder wall in response to a urolith (urinary calculus; bladder stone). Pending permission from Brian Smyth. | 1 |
| 11:50, 31 August 2007 | Myofibrillar hypoplasia.jpg (file) |  |
25 KB | Lizzies | Myofibrillar hypoplasia in the piglet. Pending permission from Brian Smyth. | 1 |
| 12:00, 31 August 2007 | Case pic 3.jpg (file) |  |
79 KB | Kjr35 | 1 | |
| 12:00, 31 August 2007 | Hyperplastic nodule liver.jpg (file) |  |
26 KB | Lizzies | Hyperplastic nodule in the liver of an elderly dog. Pending permission from Brian Smyth. | 1 |
| 12:04, 31 August 2007 | Benign prostatic hyperplasia.jpg (file) |  |
89 KB | Lizzies | Benign prostatic hyperplasia (man). Courtesy of BioMed Archive. | 1 |
| 12:04, 31 August 2007 | Case pic 4.jpg (file) |  |
78 KB | Kjr35 | 1 | |
| 12:13, 31 August 2007 | Mammary tumour ossification.jpg (file) |  |
59 KB | Lizzies | Bone formation in a mixed mammary tumour. Pending permission from Brian Smyth. | 1 |
| 12:18, 31 August 2007 | Renal dysplasia dog gross.jpg (file) |  |
24 KB | Lizzies | Gross apperarance of renal dysplasia in the dog. Pending permission from Brian Smyth. | 1 |
| 12:18, 31 August 2007 | Renal dysplasia dog histological.jpg (file) |  |
31 KB | Lizzies | Histological appearance of renal dysplasia in the dog. Note the abnormally formed glomeruli and fibrosis. Pending permission from Brian Smyth. | 1 |
| 12:21, 31 August 2007 | Anaplatic carcinoma.jpg (file) | |
41 KB | Lizzies | Anaplastic carcinoma. Pending permission from Brian Smyth. | 1 |
| 15:34, 31 August 2007 | Bronchiolitis.jpg (file) |  |
18 KB | Bara | 1 | |
| 15:36, 31 August 2007 | COPD.jpg (file) |  |
18 KB | Bara | 1 | |
| 15:37, 31 August 2007 | COPD scanning micrograph.jpg (file) |  |
17 KB | Bara | 1 | |
| 15:40, 31 August 2007 | Dictyocaulus viviparus.jpg (file) |  |
15 KB | Bara | 1 | |
| 15:43, 31 August 2007 | Diffuse fibrosing alveolitis.jpg (file) |  |
13 KB | Bara | 1 | |
| 15:45, 31 August 2007 | Echinococcus cysts.jpg (file) |  |
15 KB | Bara | 1 | |
| 15:46, 31 August 2007 | Fog fever 1.jpg (file) |  |
11 KB | Bara | 1 | |
| 15:46, 31 August 2007 | Fog fever 2.jpg (file) |  |
15 KB | Bara | 1 | |
| 15:49, 31 August 2007 | Interstitial emphysema.jpg (file) |  |
13 KB | Bara | 1 | |
| 15:49, 31 August 2007 | Interstitial emphysema micro.jpg (file) |  |
15 KB | Bara | 1 | |
| 15:50, 31 August 2007 | Pulmonary haemorrhage.jpg (file) |  |
19 KB | Bara | 1 | |
| 15:51, 31 August 2007 | Pulmonary infarction.jpg (file) |  |
20 KB | Bara | 1 | |
| 15:54, 31 August 2007 | Paraquat poisoning.jpg (file) |  |
14 KB | Bara | 1 | |
| 15:59, 31 August 2007 | Parasitic bronchitis.jpg (file) |  |
15 KB | Bara | 1 | |
| 16:09, 31 August 2007 | Parasitic pneumonia.jpg (file) |  |
12 KB | Bara | 1 | |
| 16:11, 31 August 2007 | Pulmonary carcinoma.jpg (file) |  |
19 KB | Bara | 1 | |
| 11:14, 3 September 2007 | Benign leiomyoma.jpg (file) |  |
25 KB | Lizzies | Benign neoplasm (leiomyoma). Note that the growth is encapsulated. Pending permission from Brian Smyth. | 1 |
| 11:17, 3 September 2007 | Perianal gland hepatoid adenoma dog.jpg (file) |  |
37 KB | Lizzies | Perianal gland "hepatoid" adenoma in the dog (benign). Note the well differentiated cells, that resemble hepatocytes. The tissue is well organised, there are few mitoses and there is no haemoorhage or necrosis. Pending permission from Brian Smyth. | 1 |
| 11:31, 3 September 2007 | Haemangioscarcoma flank.jpg (file) |  |
57 KB | Lizzies | Haemangiosarcoma (malignant) in the flank of a dog. Pending permission from Brian Smyth. | 1 |
| 11:32, 3 September 2007 | Haemangioscarcoma lung metastases.jpg (file) |  |
38 KB | Lizzies | Metastases in the lung of the dog, from haemangiosarcoma of the flank. Malignant tumours can, and some readily do, spread to local lymph nodes and the lungs. Pending permssion from Brian Smyth. | 1 |
| 11:36, 3 September 2007 | Haemangioscarcoma histo.jpg (file) |  |
58 KB | Lizzies | Histological appearance of malignant endothelium. Malignant tumours tend to appear more anaplastic and basophilic, and have a higher nucleus:cytoplasm ratio. Pending permission from Brian Smyth. | 1 |
| 11:42, 3 September 2007 | Abnormal mitoses.jpg (file) |  |
17 KB | Lizzies | Abnormal mitoses. Pending permission from Brian Smyth. | 1 |
| 11:44, 3 September 2007 | Profuse fibrosis.jpg (file) |  |
37 KB | Lizzies | Profuse fibrosis in mammary adenocarcinoma. Pending permission from Brian Smyth. | 1 |
| 11:53, 3 September 2007 | Adenocarcinoma metastasis to lymph node.jpg (file) |  |
52 KB | Lizzies | Histological appearance of lymphatic spread of adenocarcinoma to the lymph nodes. Pending permission from Brian Smyth. | 1 |